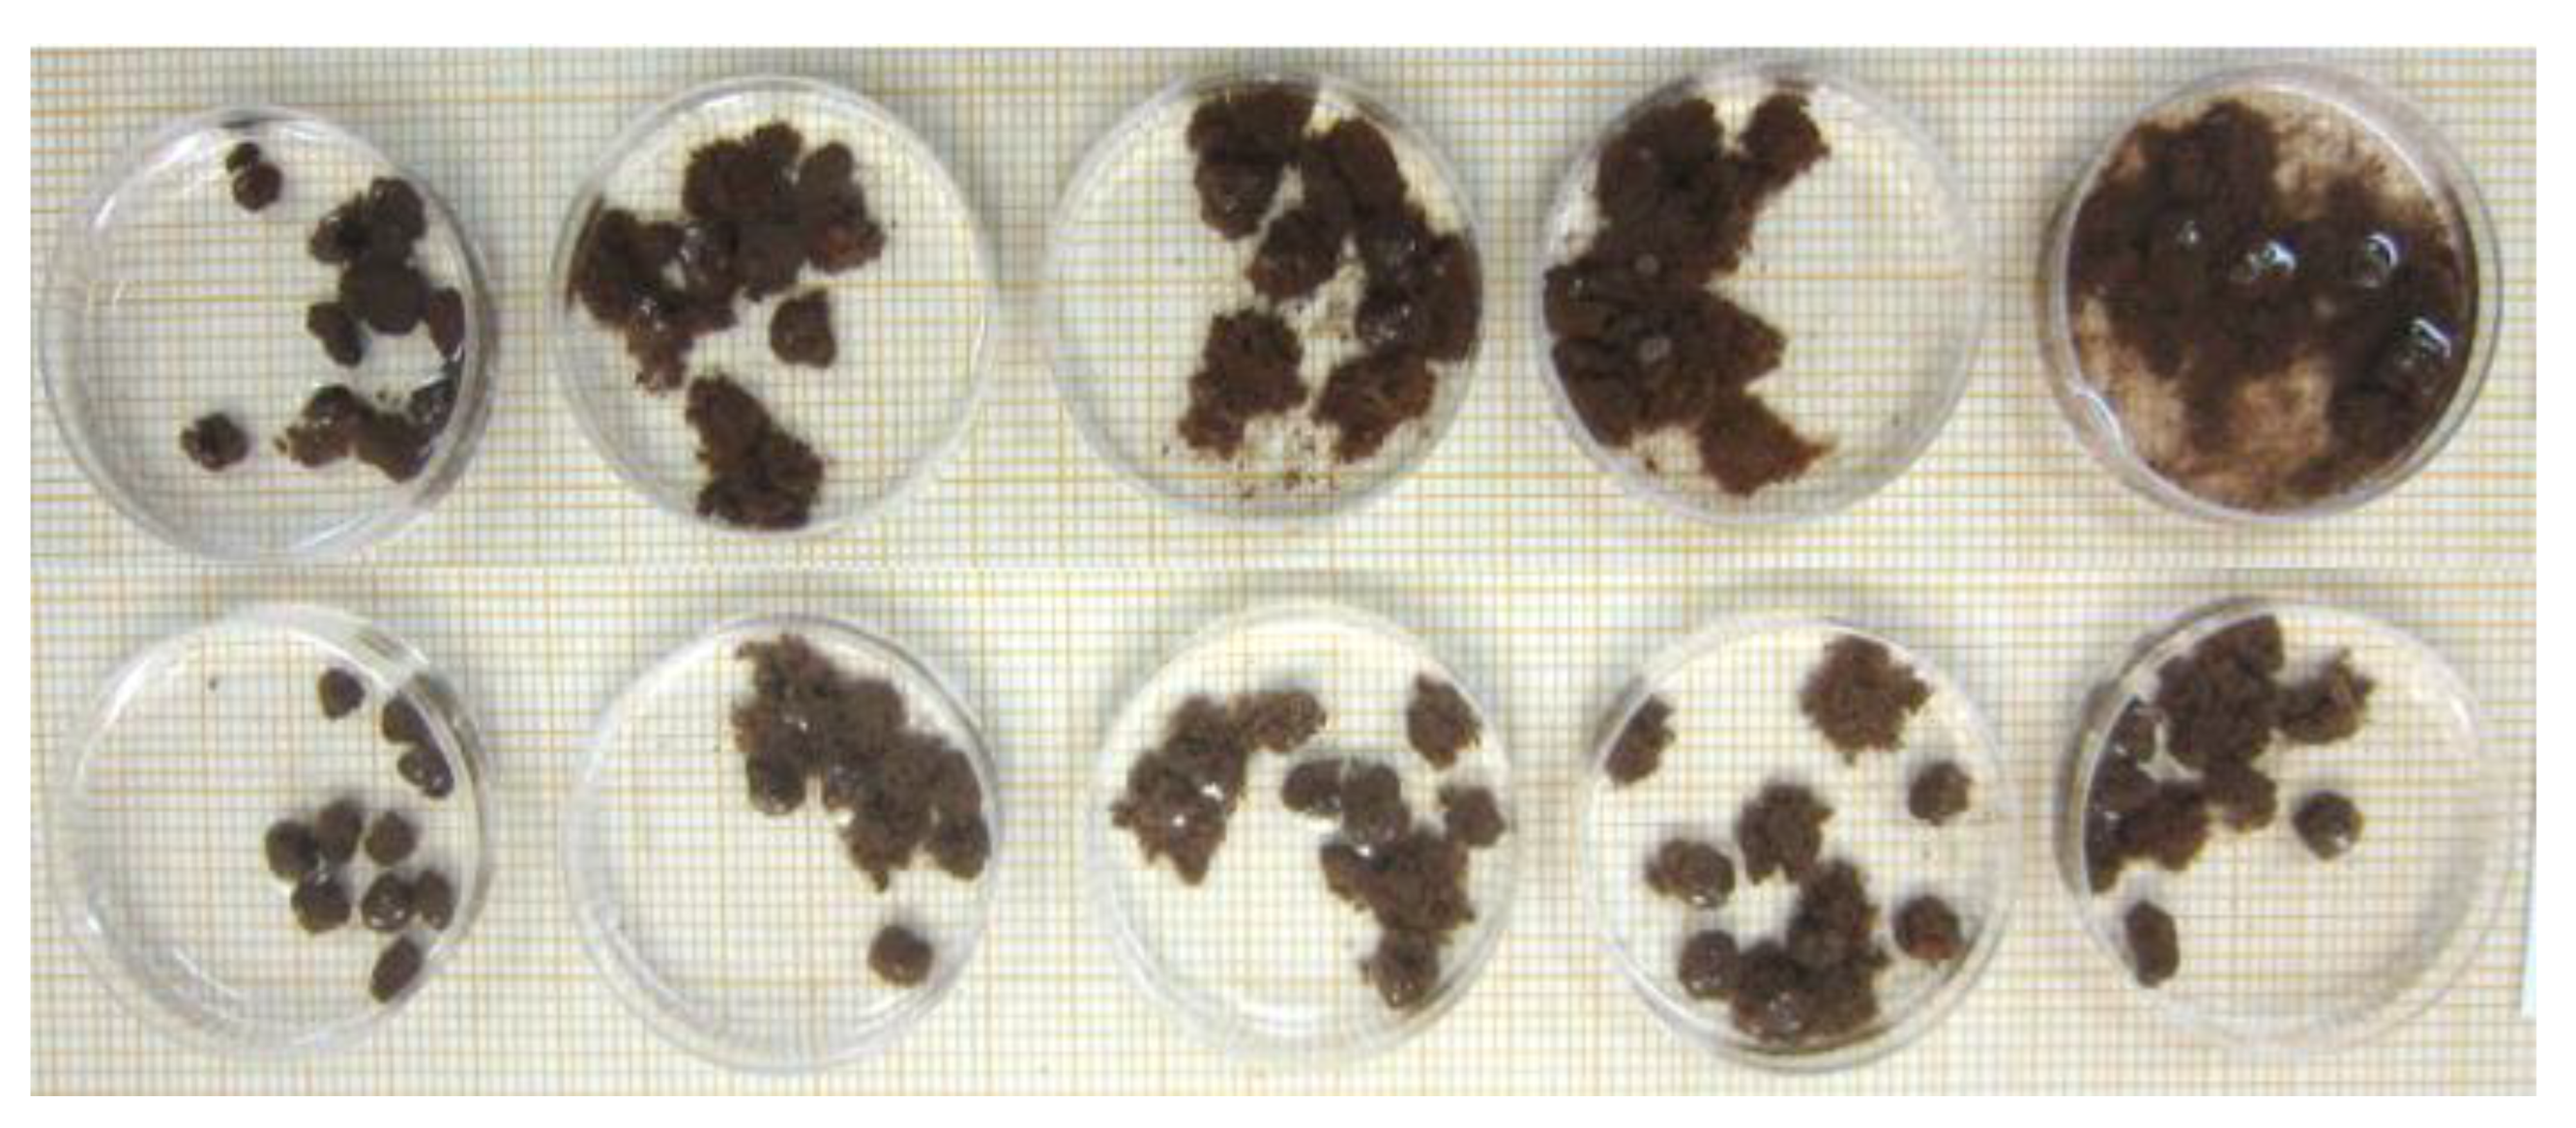
Sustainability 15 13060 g003

Citrus Orchards in Agroforestry, Organic, and Conventional Systems: Soil Quality and Functioning
Abstract
1. Introduction
2. Materials and Methods
2.1. Citrus Farming System and Forest Site Description
2.2. Soil Sampling
2.3. Soil Chemical Analysis
2.4. Soil Physical Analysis
2.4.1. Granulometry, Soil Bulk Density, and Particle Density
2.4.2. Soil Water Retention Curve, Macroporosity, and Microporosity
2.4.3. Stability of Soil Aggregates
2.5. Biological Analysis
2.5.1. Hydrolysis of Fluorescein Diacetate (FDA)
2.5.2. Bait Blade
2.6. Statistical Analysis
3. Results
3.1. Soil Chemical Properties
3.2. Soil Physical Properties
3.3. Soil Biological Properties
4. Discussion
4.1. Soil Chemical Properties
4.2. Soil Physical Properties
4.3. Soil Biological Properties
5. Conclusions
Author Contributions
Funding
Institutional Review Board Statement
Informed Consent Statement
Data Availability Statement
Acknowledgments
Conflicts of Interest
Appendix A
| Land Use | pH in Water | |||||||
|---|---|---|---|---|---|---|---|---|
| Period 1 (Spring 2014) | Period 2 (Summer 2015) | Period 3 (Winter/Spring 2015) | Period 4 (Spring/Summer 2015) | |||||
| σ | σ | σ | σ | |||||
| Layer 0–0.05 m | ||||||||
| Cc | 5.94 | 0.14 | 5.34 | 0.17 | 5.67 | 0.28 | 5.70 | 0.36 |
| Co | 6.75 | 0.22 | 6.69 | 0.02 | 6.22 | 0.11 | 6.22 | 0.10 |
| Cs | 6.92 | 0.19 | 6.62 | 0.12 | 6.45 | 0.33 | 6.51 | 0.10 |
| F40 | 5.02 | 0.29 | 5.03 | 0.34 | 4.86 | 1.05 | 4.68 | 1.12 |
| F200 | 5.00 | 0.17 | 4.67 | 0.25 | 5.35 | 0.57 | 5.21 | 0.63 |
| C1 | * | * | * | * | ||||
| C2 | * | * | * | * | ||||
| C3 | ns | ns | ns | ns | ||||
| C4 | ns | * | ns | ns | ||||
| Layer 0.05–0.20 m | ||||||||
| Cc | 5.24 | 0.20 | 4.78 | 0.10 | 4.92 | 0.33 | 4.99 | 0.22 |
| Co | 6.93 | 0.33 | 6.50 | 0.09 | 6.67 | 0.32 | 6.68 | 0.36 |
| Cs | 7.18 | 0.22 | 6.43 | 0.14 | 6.49 | 0.39 | 6.41 | 0.37 |
| F40 | 4.80 | 0.24 | 4.78 | 0.34 | 4.55 | 0.23 | 4.53 | 0.06 |
| F200 | 4.68 | 0.45 | 4.61 | 0.41 | 4.68 | 0.77 | 4.71 | 0.72 |
| C1 | * | * | * | * | ||||
| C2 | * | * | * | * | ||||
| C3 | ns | ns | ns | ns | ||||
| C4 | ns | ns | ns | ns | ||||
| Layer 0.2–0.40 m | ||||||||
| Cc | 4.94 | 0.12 | 4.72 | 0.09 | 4.79 | 0.16 | 5.03 | 0.44 |
| Co | 6.30 | 0.28 | 5.99 | 0.28 | 6.13 | 0.62 | 6.08 | 0.73 |
| Cs | 6.89 | 0.20 | 6.45 | 0.15 | 6.14 | 0.19 | 6.18 | 0.28 |
| F40 | 4.73 | 0.15 | 4.83 | 0.17 | 4.85 | 0.72 | 4.83 | 0.54 |
| F200 | 4.92 | 0.41 | 4.70 | 0.46 | 4.74 | 0.55 | 4.49 | 0.38 |
| C1 | * | * | * | * | ||||
| C2 | * | * | * | * | ||||
| C3 | * | * | ns | ns | ||||
| C4 | ns | ns | ns | ns | ||||






References
- Cunha, J.E.F.; Bravo, J.V.M. Effects of environmental protection policies on fragile areas of a watershed occupied by agriculture in the Brazilian Cerrado. J. Environ. Manag. 2022, 319, 115695. [Google Scholar] [CrossRef]
- Maia, A.G.; Miyamoto, B.C.B.; Garcia, J.R. Climate Change and Agriculture: Do Environmental Preservation and Ecosystem Services Matter? Ecol. Econ. 2018, 152, 27–39. [Google Scholar] [CrossRef]
- Sadowski, A.; Baer-Nawrocka, A. Food and environmental function in world agriculture—Interdependence or competition? Land. Use Policy 2018, 71, 578–583. [Google Scholar] [CrossRef]
- David, P.; Schneider, M. Sustainability of food security in different cacao production systems: A land, labour, energy and food quality nexus approach. Resour. Conserv. Recycl. 2023, 190, 106874. [Google Scholar] [CrossRef]
- Kharel, M.; Dahal, B.M. Good agriculture practices for safe food and sustainable agriculture in Nepal: A review. J. Agric. Food Res. 2022, 10, 100447. [Google Scholar] [CrossRef]
- Pellegrino, E.; Piazza, G. Microbiome structure and interconnection in soil aggregates across conservation and conventional agricultural practices allow to identify main prokaryotic and fungal taxa related to soil functioning. Soil. Biol. Biochem. 2022, 175, 108833. [Google Scholar] [CrossRef]
- Piazza, G.; Pellegrino, E. Long-term conservation tillage and nitrogen fertilization effects on soil aggregate distribution, nutrient stocks and enzymatic activities in bulk soil and occluded microaggregates. Soil. Tillage Res. 2020, 196, 104482. [Google Scholar] [CrossRef]
- Yifru, A.; Taye, B. Effects of landuse on soil organic carbon and nitrogen in soils of bale, Southeastern Ethiopia. Trop. Subtrop. Agroecosystems 2011, 14, 229–235. [Google Scholar]
- Six, J.; Conant, R.T. Stabilization mechanisms of soil organic matter: Implications for C-saturation of soils. Plant Soil. 2002, 24, 155–176. [Google Scholar] [CrossRef]
- Wacker, T.S.; Jensen, L.S. Conservation agriculture affects soil organic matter distribution, microbial metabolic capacity and nitrogen turnover under Danish field conditions. Soil. Tillage Res. 2022, 224, 105508. [Google Scholar] [CrossRef]
- Alletto, L.; Cueff, S. Physical properties of soils under conservation agriculture: A multi-site experiment on five soil types in south-western France. Geoderma 2022, 428, 116228. [Google Scholar] [CrossRef]
- Marriott, E.E.; Wander, M. Qualitative and quantitative differences in particulate organic matter fractions in organic and conventional farming systems. Soil. Biol. Biochem. 2006, 38, 1527–1536. [Google Scholar] [CrossRef]
- Baldock, J.A.; Creamer, C. Linking decomposition rates of soil organic amendments to their chemical composition. Soil. Res. 2021, 59, 630–643. [Google Scholar] [CrossRef]
- Blume, E.; Reichert, J.M. Banana leaf and glucose mineralization and soil organic matter in microhabitats of banana plantations under long-term pesticide use: Pesticides, soil organic matter, and microbes in banana crop. Environ. Toxicol. Chem. 2015, 34, 1232–1238. [Google Scholar] [CrossRef]
- Teixeira, H.M.; Bianchi, F.J.J.A. Impact of agroecological management on plant diversity and soil-based ecosystem services in pasture and coffee systems in the Atlantic forest of Brazil. Agric. Ecosyst. Environ. 2021, 305, 107171. [Google Scholar] [CrossRef]
- Loranger-Merciris, G.; Ozier-Lafontaine, H. Fast improvement of macrofauna communities and soil quality in plantain crops converted to agroecological practices. Pedobiologia 2022, 93–94, 150823. [Google Scholar] [CrossRef]
- Palomo-Campesino, S.; García-Llorente, M. Do agroecological practices enhance the supply of ecosystem services? A comparison between agroecological and conventional horticultural farms. Ecosyst. Serv. 2022, 57, 101474. [Google Scholar] [CrossRef]
- Declerck, F.R.; Chazdon, R.L. Biodiversity conservation in human-modified landscapes of Mesoamerica: Past, present, and future. Biol. Conserv. 2010, 143, 2301–2313. [Google Scholar] [CrossRef]
- Harvey, C.A.; Komar, O. Integrating agricultural landscapes with biodiversity conservation in the Mesoamerican hotspot. Biol. Conserv. 2008, 22, 8–15. [Google Scholar] [CrossRef]
- Garrity, D.P.; Akinifesi, F.K. Evergreen agriculture: A robust approach to sustainable food security in Africa. Food Secur. 2010, 2, 197–214. [Google Scholar] [CrossRef]
- van der Ploeg, J.D.; Barjolle, D. The economic potential of agroecology: Empirical evidence from Europe. J. Rural. Stud. 2019, 71, 46–61. [Google Scholar] [CrossRef]
- Van Leeuwen, J.P.; Lehtinen, T. An ecosystem approach to assess soil quality in organically and conventionally managed farms in Iceland and Austria. Soil 2015, 1, 83–101. [Google Scholar] [CrossRef]
- Borges, A.L.; Trindade, A.V. Cultivo Orgânico de Fruteiras Tropicais: Manejo do Solo e da Cultura; Circular 64; Embrapa Mandioca e Fruticultura: Cruz das Almas, Brazil, 2003. [Google Scholar]
- Raupp, J.; Oltmanns, M. Organically fertilized plants can manage water-limited growth conditions better than minerally fertilized plants, Results from Multi-year experiment. In Proceedings of the 17th International Symposium of CIEC, NRC, Cairo, Egypt, 24–27 November 2008; pp. 159–164. [Google Scholar]
- Coyne, M.S.; Pena-Yewtukhiw, E.M. Soil health—It’s not all biology. Soil. Secur. 2022, 6, 100051. [Google Scholar] [CrossRef]
- Das, S.; Bhattacharyya, R. Soil aggregate-associated carbon and organic carbon pools as affected by conversion of forest lands to agriculture in an acid soil of India. Soil. Tillage Res. 2022, 223, 105443. [Google Scholar] [CrossRef]
- Guhra, T.; Stolze, K. Pathways of biogenically excreted organic matter into soil aggregates. Soil. Biol. Biochem. 2022, 164, 108483. [Google Scholar] [CrossRef]
- Loss, A.; Lourenzi, C.R. Carbon, nitrogen and natural abundance of 13C and 15N in biogenic and physicogenic aggregates in a soil with 10 years of pig manure application. Soil. Tillage Res. 2017, 166, 52–58. [Google Scholar] [CrossRef]
- Rodríguez, L.; Suárez, J.C. Agroforestry systems impact soil macroaggregation and enhance carbon storage in Colombian deforested Amazonia. Geoderma 2021, 384, 114810. [Google Scholar] [CrossRef]
- Köppen, W. Climatologia: Con un Estudio de los Climas de la Tierra; Fondo de Cultura Economica: Mexico City, Mexico, 1948; p. 478. [Google Scholar]
- Santos, H.G.; Jacomine, P.K.T. Sistema Brasileiro de Classificação de Solos, 5th ed.; Embrapa: Brasilia, Brazil, 2018; p. 356. [Google Scholar]
- Soil Survey Staff. Soil Taxonomy: A Basic System of Soil Classification for Making and Interpreting Soil Surveys, 2nd ed.; Natural Resources Conservation Service, U.S. Department of Agriculture Handbook; U.S. Department of Agriculture: Washington, DC, USA, 1999; p. 436. [Google Scholar]
- Pietrzacka, R. Caracterização Física e Química de um Argissolo em Área de Citricultura Orgânica com Diferentes Manejos da Cobertura Vegetal do Solo. Master’s Thesis, The Federal University of Rio Grande do Sul, Porto Alegre, Brazil, 2009. Programa de Pós-Graduação em Ciência do Solo. p. 106. [Google Scholar]
- Tedesco, M.J.; Gianello, C. Análise de Solo, Plantas e Outros Materiais, 2nd ed.; Universidade Federal do Rio Grande do Sul: Porto Alegre, Brazil, 1995; p. 147. [Google Scholar]
- Toledo, J.A.; Kaminski, J. Tampão Santa Maria (TSM) como alternativa ao tampão SMP para medição da acidez potencial de solos ácidos. Rev. Bras. Cienc. Solo 2012, 36, 427–435. [Google Scholar] [CrossRef]
- Mebius, L.J. A rapid method for the determination of organic carbon in soil. Anal. Chim. Acta 1960, 22, 120–124. [Google Scholar] [CrossRef]
- Embrapa; Centro Nacional de Pesquisa de Solos. Manual de Métodos de Análise de Solo, 2nd ed.; Embrapa: Rio de Janeiro, Brazil, 1997; p. 212. [Google Scholar]
- Suzuki, L.E.A.S.; Reichert, J.M. Dispersion and flocculation of Vertisols, Alfisols and Oxisols in Southern Brazil. Geoderma Reg. 2015, 5, 64–70. [Google Scholar] [CrossRef]
- Gubiani, P.I.; Reinert, D.J. Método alternativo para a determinação da densidade de partículas do solo—Exatidão, precisão e tempo de processamento. Ciênc Rural. 2006, 36, 664–668. [Google Scholar] [CrossRef]
- Reinert, D.J.; Reichert, J.M. Coluna de areia para medir a retenção de água no solo—Protótipos e teste. Ciênc Rural. 2006, 36, 1931–1935. [Google Scholar] [CrossRef]
- Gubiani, P.I.; Albuquerque, J.A. Tensão e extração de água em mesa de tensão e coluna de areia, em dois solos com elevada densidade. Ciênc Rural. 2009, 39, 2535–2538. [Google Scholar] [CrossRef]
- Klute, A. Water retention: Laboratory methods. In Methods of Soil Analysis I. Physical and Mineralogical Methods; Black, C.A., Ed.; American Society of Agronomy, Soil Science Society of America: Madison, WI, USA, 1986; pp. 635–662. [Google Scholar]
- Gubiani, P.I.; Reichert, J.M. Assessing errors and accuracy in dew-point potentiometer and pressure plate extractor measurements. Soil. Sci. Soc. Am. J. 2013, 77, 19–24. [Google Scholar] [CrossRef]
- Goebel, M.; Woche, S.K. Quantitative analysis of liquid penetration kinetics and slaking of aggregates as related to solid–liquid interfacial properties. J. Hydrol. 2012, 63, 442–443. [Google Scholar] [CrossRef]
- Green, V.S.; Stott, D.E. Assay for fluorescein diacetate hydrolytic activity: Optimization for soil samples. Soil. Biol. Biochem. 2006, 38, 693–701. [Google Scholar] [CrossRef]
- Törne, E. Assessing feeding activities of soil-living animals I. Bait-lamina-testes. Pedobiologia 1990, 34, 89–101. [Google Scholar]
- Kratz, W. The bait-lamina test. General aspects, applications and perspectives. Environ. Sci. Pollut. Res. 1998, 5, 94–96. [Google Scholar] [CrossRef]
- Podgaiski, L.R.; Silveira, F.S. Avaliação da atividade alimentar dos invertebrados de solo em campos do sul do Brasil—Bait-lamina Test. Entomo Bras. 2011, 4, 108–113. [Google Scholar] [CrossRef][Green Version]
- Römbke, J.H.; Hofer, M.V.B. Feeding activities of soil organisms at four different forest sites in Central Amazonia using the bait-lamina method. J. Trop. Ecol. 2006, 22, 313–320. [Google Scholar] [CrossRef]
- Stevenson, F.J. Humus Chemistry: Genesis, Composition, Reactions; John Wiley & Sons: New York, NY, USA, 1982. [Google Scholar]
- Stockdale, E.A.; Shepherd, M.A. Fortune S and Cuttle SP, Soil fertility in organic farming systems—Fundamentally different? Soil. Use Manag. 2002, 18, 301–308. [Google Scholar] [CrossRef]
- Bulluck III, L.R.; Brosius, M. Organic and synthetic fertility amendments influence soil microbial, physical and chemical properties on organic and conventional farms. Appl. Soil. Ecol. 2002, 19, 147–160. [Google Scholar] [CrossRef]
- Drinkwater, L.E.; Wagoner, P. Legume-based cropping systems have reduced carbon and nitrogen losses. Nature 1998, 396, 262–265. [Google Scholar] [CrossRef]
- Hondebrink, M.A.; Cammeraat, L.H. The impact of agricultural management on selected soil properties in citrus orchards in Eastern Spain: A comparison between conventional and organic citrus orchards with drip and flood irrigation. Sci. Total Environ. 2017, 581–582, 153–160. [Google Scholar] [CrossRef] [PubMed]
- Chenu, C.; Angers, D.A. Increasing organic stocks in agricultural soils: Knowledge gaps and potential innovations. Soil. Tillage Res. 2019, 188, 41–52. [Google Scholar] [CrossRef]
- Silva, D.C.; Silva, M.L.N. Atributos do solo em sistemas agroflorestais, cultivo convencional e floresta nativa. Rev. Estud. Ambient. 2011, 13, 77–86. [Google Scholar]
- Reichert, J.M.; Rodrigues, M.F. Fragmentation, fiber separation, decomposition, and nutrient release of secondary-forest biomass, mechanically chopped-and-mulched, and cassava production in the Amazon. Agric. Ecosyst. Environ. 2015, 204, 8–16. [Google Scholar] [CrossRef][Green Version]
- Carvalho, R.; Goedert, W.J. Atributos físicos da qualidade de um solo sob sistema agroflorestal. Pesq. Agropec Bras. 2004, 39, 1153–1155. [Google Scholar] [CrossRef][Green Version]
- Pilon, L.C. Atributos de um Argissolo Amarelo Coeso sob Cultivo de Cafeeiro a Pleno sol e Consorciado com Espécies Arbóreas. Master’s Thesis, Universidade Federal do Espírito Santo, Vitória, Brazil, 2013. Programa de Pós Graduação em Produção Vegetal. p. 104. [Google Scholar]
- Tisdall, J.M.; Oades, J.M. Stabilization of soil aggregates by the root systems of ryegrass. Austr J. Soil. Res. 1979, 17, 429–441. [Google Scholar] [CrossRef]
- Palmeira, P.R.T.; Pauletto, E.A. Agregação de um Planossolo submetido a diferentes sistemas de cultivo. Rev. Bras. Cienc. Solo 1999, 23, 189–195. [Google Scholar] [CrossRef]
- Are, M.; Kaart, T. The effects of crops together with winter cover crops on the content of soil water-stable aggregates in organic farming. Agriculture 2021, 11, 1035. [Google Scholar] [CrossRef]
- Schäfer, M.J.; Reichert, J.M. Erosão em sulcos em diferentes preparos e estados de consolidação do solo. Rev. Bras. Cienc. Solo 2001, 25, 19–430. [Google Scholar] [CrossRef]
- Schäfer, M.J.; Reichert, J.M. Erosão em entressulcos em diferentes preparos e estados de consolidação do solo. Rev. Bras. Cienc. Solo 2001, 25, 431–441. [Google Scholar] [CrossRef][Green Version]
- Awe, G.O.; Reichert, J.M. Temporal variability and covariance structures of soil temperature in a sugarcane field under different management practices in southern Brazil. Soil. Tillage Res. 2015, 150, 93–106. [Google Scholar] [CrossRef]
- Awe, G.O.; Reichert, J.M. Temporal processes of soil water status in a sugarcane field under residue management. Plant Soil. 2015, 387, 395–411. [Google Scholar] [CrossRef]
- Ambus, J.V.; Awe, G.O. Integrated crop-livestock systems in lowlands with rice cultivation improve root environment and maintain soil structure and functioning. Soil. Tillage Res. 2023, 227, 105592. [Google Scholar] [CrossRef]
- Campos, B.C.; Reinert, D.J. Estabilidade estrutural de um Latossolo Vermelho-Escuro distrófico após sete anos de rotação de culturas e sistemas de manejo do solo. Rev. Bras. Cienc. Solo 1995, 19, 121–126. [Google Scholar]
- Wendling, B.; Jucksch, I. Carbono orgânico e estabilidade de agregados de um Latossolo Vermelho sob diferentes manejos. Pesq. Agropec Bras. 2005, 40, 487–494. [Google Scholar] [CrossRef]
- Reichert, J.M.; Norton, L.D. Aggregate stability and rain-impacted sheet erosion of air-dried and prewetted clayey surface soils under intense rain. Soil. Sci. 1994, 158, 159–169. [Google Scholar] [CrossRef]
- Bayer, C.; Mielniczuk, J. Nitrogênio total de um solo submetido a diferentes métodos de preparo e sistemas de cultura. Rev. Bras. Cienc. Solo 1997, 21, 235–239. [Google Scholar]
- Reichert, J.M.; Corcini, A.L. Onion-forage cropping systems on a Vertic Argiudoll in Uruguay: Onion yield and soil organic matter, aggregation, porosity and permeability. Soil. Tillage Res. 2022, 216, 105229. [Google Scholar] [CrossRef]
- Wohlenberg, E.V.; Reichert, J.M. Dinâmica da agregação de um solo franco-arenoso em cinco sistemas de culturas em rotação e em sucessão. Rev. Bras. Cienc. Solo 2004, 28, 891–900. [Google Scholar] [CrossRef]
- Weiler, D.A.; Moro, V.J. Carbon balance in sugarcane areas under different tillage systems. BioEnergy Res. 2019, 12, 778–788. [Google Scholar] [CrossRef]
- Reichert, J.M.; Albuquerque, J.A. Estimation of water retention and availability in soils of Rio Grande do Sul. Rev. Bras. Cienc. Solo 2009, 33, 1547–1560. [Google Scholar] [CrossRef]
- Reichert, J.M.; Prevedello, J. Eucalyptus tree stockings effect on water balance and use efficiency in subtropical sandy soil. Ecol. Manag. 2021, 497, 119473. [Google Scholar] [CrossRef]
- Cavalli, J.P.; de Araújo, E. Eucalyptus growth responses to soil water storage capacity in Arenosols and Acrisols soils: Wood and biomass stock modelling. Sustainability 2022, 14, 12215. [Google Scholar] [CrossRef]
- Vaz, C.M.P.; de Freitas Iossi, M. Validation of the Arya and Paris water retention model for Brazilian soils. Soil. Sci. Soci. Am. J. 2005, 69, 577–583. [Google Scholar] [CrossRef]
- Reichert, J.M.; Rodrigues, M.F. Fire-free fallow management by mechanized chopping of biomass for sustainable agriculture in eastern Amazon: Effects on soil compactness, porosity, and water retention and availability. Land. Degrad. Dev. 2016, 27, 1403–1412. [Google Scholar] [CrossRef]
- Reichert, J.M.; Bervald, C.M.P. Mechanized land preparation in eastern Amazon in fire-free forest-based fallow systems as alternatives to slash-and-burn practices: Hydraulic and mechanical soil properties. Agric. Ecosyst. Environ. 2014, 192, 47–60. [Google Scholar] [CrossRef]
- Amorim, R.S.S.; Albuquerque, J.A. Water retention and availability in Brazilian Cerrado (Neotropical savanna) soils under agricultural use: Pedotransfer functions and decision trees. Soil. Tillage Res. 2022, 224, 105485. [Google Scholar] [CrossRef]
- Braida, J.A.; Bayer, C. Matéria orgânica e seu efeito na física do solo. Tópicos Ciênc Solo 2011, 7, 221–278. [Google Scholar]
- Coleman, C.; Crossley, D.A.J.R. Fundamentals of Soil Ecology; Academic Press: San Diego, CA, USA, 2004; p. 384. [Google Scholar]
- Lavelle, P. Diversity of soil fauna and ecosystem function. Biol. Int. 1996, 33, 3–16. [Google Scholar]
- Hättenschwiler, S.; Tiunov, A.V. Biodiversity and litter decomposition in terrestrial ecosystems. Annu. Rev. Ecol. Evol. Syst. 2005, 36, 191–218. [Google Scholar] [CrossRef]
- Gongalsky, K.B.; Pokarzhevskii, D.A. Stratification and dynamics of bait-lamina perforation in three forest soils along a north–south gradient in Russia. Appl. Soil. Ecol. 2004, 25, 111–122. [Google Scholar] [CrossRef]
- Pessotto, M.D.F.; Santana, N.A. Relação do uso do solo com a diversidade e a atividade da fauna edáfica. Nativa 2020, 8, 397–402. [Google Scholar] [CrossRef]

| Contrasts | Systems of Use and Management | ||||
|---|---|---|---|---|---|
| F200 | F40 | Cs | Co | Cc | |
| C1 | 1.5 | 1.5 | −1 | −1 | −1 |
| C2 | 0 | 0 | 1 | 1 | −2 |
| C3 | 0 | 0 | 1 | −1 | 0 |
| C4 | 1 | −1 | 0 | 0 | 0 |
| Land Use | pH in Water | pH TSM | Available P | CEC Effective | CEC pH 7 | |||||
|---|---|---|---|---|---|---|---|---|---|---|
| (mg dm−3) | cmolc dm−3 | cmolc dm−3 | ||||||||
| σ | σ | Σ | σ | Σ | ||||||
| Layer 0–0.05 m | ||||||||||
| Cc | 5.7 | 0.18 | 7.0 | 0.07 | 58.2 | 13.90 | 1.4 | 0.20 | 1.9 | 0.26 |
| Co | 6.5 | 0.09 | 7.0 | 0.08 | 134.4 | 43.64 | 4.2 | 0.40 | 5.0 | 0.44 |
| Cs | 6.6 | 0.10 | 6.9 | 0.12 | 153.5 | 19.12 | 4.9 | 0.50 | 5.7 | 0.58 |
| F40 | 4.9 | 0.29 | 6.4 | 0.44 | 16.3 | 10.60 | 2.2 | 0.37 | 2.9 | 0.32 |
| F200 | 5.1 | 0.24 | 6.4 | 0.20 | 6.1 | 0.80 | 2.6 | 1.28 | 3.4 | 0.93 |
| C1 | * | * | * | * | * | |||||
| C2 | * | ns | * | * | * | |||||
| C3 | ns | ns | ns | ns | ns | |||||
| C4 | ns | ns | ns | ns | ns | |||||
| Layer 0.05–0.20 m | ||||||||||
| Cc | 5.0 | 0.13 | 6.7 | 0.26 | 46.8 | 17.35 | 0.7 | 0.10 | 1.1 | 0.05 |
| Co | 6.7 | 0.19 | 7.5 | 0.06 | 23.2 | 11.23 | 1.3 | 0.46 | 1.7 | 0.60 |
| Cs | 6.6 | 0.13 | 7.1 | 0.33 | 32.1 | 9.92 | 1.6 | 0.37 | 2.0 | 0.41 |
| F40 | 4.7 | 0.12 | 6.4 | 0.28 | 10.1 | 8.15 | 1.1 | 0.24 | 1.7 | 0.11 |
| F200 | 4.7 | 0.41 | 6.2 | 0.55 | 3.1 | 0.49 | 1.7 | 0.59 | 3.3 | 0.71 |
| C1 | * | * | * | ns | * | |||||
| C2 | * | * | * | * | * | |||||
| C3 | ns | ns | ns | ns | ns | |||||
| C4 | ns | ns | ns | * | * | |||||
| Layer 0.20–0.40 m | ||||||||||
| Cc | 4.9 | 0.11 | 6.4 | 0.27 | 34.4 | 13.00 | 0.6 | 0.21 | 1.4 | 0.13 |
| Co | 6.1 | 0.31 | 7.3 | 0.24 | 3.6 | 0.97 | 0.7 | 0.02 | 0.9 | 0.01 |
| Cs | 6.4 | 0.12 | 7.1 | 0.20 | 5.3 | 1.99 | 0.9 | 0.12 | 1.2 | 0.44 |
| F40 | 4.8 | 0.24 | 6.5 | 0.40 | 7.6 | 5.15 | 1.1 | 0.25 | 1.8 | 0.17 |
| F200 | 4.7 | 0.24 | 6.3 | 0.62 | 2.8 | 0.14 | 1.4 | 0.27 | 3.3 | 0.56 |
| C1 | * | * | * | * | * | |||||
| C2 | * | * | * | ns | ns | |||||
| C3 | ns | ns | ns | ns | ns | |||||
| C4 | ns | ns | ns | * | * | |||||
| Land Use | Sand (%) | Silt (%) | Clay (%) | |||
|---|---|---|---|---|---|---|
| σ | σ | σ | ||||
| Layer 0–0.05 m | ||||||
| Cc | 89.9 | 1.3 | 2.7 | 0.8 | 7.3 | 1.4 |
| Co | 85.1 | 3.2 | 6.2 | 1.3 | 8.7 | 2.9 |
| Cs | 84.1 | 2.4 | 7.9 | 1.8 | 8.1 | 1.1 |
| F40 | 82.5 | 4.0 | 6.1 | 2.0 | 11.4 | 3.9 |
| F200 | 83.6 | 3.0 | 5.1 | 1.6 | 11.3 | 2.4 |
| C1 | * | ns | * | |||
| C2 | * | * | ns | |||
| C3 | ns | ns | ns | |||
| C4 | ns | ns | ns | |||
| Layer 0.05–0.20 m | ||||||
| Cc | 88.8 | 2.6 | 2.8 | 0.6 | 8.4 | 2.2 |
| Co | 88.5 | 3.0 | 4.2 | 2.4 | 7.2 | 3.6 |
| Cs | 90.7 | 2.3 | 3.9 | 1.6 | 5.4 | 1.1 |
| F40 | 81.0 | 4.5 | 5.8 | 1.5 | 13.2 | 4.3 |
| F200 | 85.6 | 2.3 | 4.4 | 1.1 | 10.0 | 1.5 |
| C1 | * | * | * | |||
| C2 | ns | ns | ns | |||
| C3 | ns | ns | ns | |||
| C4 | * | ns | ns | |||
| Layer 0.2–0.40 m | ||||||
| Cc | 86.2 | 4.0 | 2.5 | 0.7 | 11.3 | 3.7 |
| Co | 88.1 | 1.9 | 3.9 | 0.6 | 8.0 | 2.2 |
| Cs | 84.7 | 2.8 | 4.5 | 2.2 | 10.7 | 2.0 |
| F40 | 77.5 | 5.0 | 5.7 | 0.6 | 16.8 | 4.7 |
| F200 | 86.5 | 3.6 | 3.8 | 1.1 | 9.6 | 3.7 |
| C1 | ns | * | * | |||
| C2 | ns | * | ns | |||
| C3 | ns | ns | ns | |||
| C4 | ns | * | * | |||
| Land Use | Bd | Tp | Mip | Map | ||||
|---|---|---|---|---|---|---|---|---|
| g cm−3 | m3 m−3 | m3 m−3 | m3 m−3 | |||||
| σ | σ | σ | σ | |||||
| Layer 0–0.05 m | ||||||||
| Cc | 1.40 | 0.08 | 0.47 | 0.03 | 0.27 | 0.03 | 0.20 | 0.04 |
| Co | 0.98 | 0.14 | 0.63 | 0.06 | 0.35 | 0.05 | 0.27 | 0.06 |
| Cs | 0.96 | 0.19 | 0.64 | 0.07 | 0.40 | 0.06 | 0.23 | 0.05 |
| F40 | 1.22 | 0.13 | 0.54 | 0.05 | 0.30 | 0.05 | 0.24 | 0.05 |
| F200 | 1.16 | 0.11 | 0.56 | 0.04 | 0.30 | 0.04 | 0.26 | 0.04 |
| C1 | * | ns | ns | ns | ||||
| C2 | * | ns | ns | ns | ||||
| C3 | ns | ns | ns | ns | ||||
| C4 | * | ns | ns | ns | ||||
| Layer 0.05–0.20 | ||||||||
| Cc | 1.64 | 0.07 | 0.38 | 0.03 | 0.21 | 0.02 | 0.17 | 0.03 |
| Co | 1.55 | 0.07 | 0.42 | 0.03 | 0.19 | 0.03 | 0.23 | 0.04 |
| Cs | 1.59 | 0.09 | 0.40 | 0.03 | 0.20 | 0.03 | 0.20 | 0.04 |
| F40 | 1.55 | 0.08 | 0.42 | 0.03 | 0.23 | 0.03 | 0.19 | 0.04 |
| F200 | 1.39 | 0.11 | 0.48 | 0.04 | 0.24 | 0.03 | 0.23 | 0.04 |
| C1 | * | * | * | * | ||||
| C2 | ns | ns | ns | ns | ||||
| C3 | ns | ns | ns | ns | ||||
| C4 | ns | ns | ns | ns | ||||
| Layer 0.20–0.40 | ||||||||
| Cc | 1.66 | 0.08 | 0.37 | 0.03 | 0.20 | 0.02 | 0.17 | 0.03 |
| Co | 1.60 | 0.08 | 0.40 | 0.03 | 0.18 | 0.02 | 0.21 | 0.03 |
| Cs | 1.75 | 0.04 | 0.34 | 0.02 | 0.18 | 0.02 | 0.16 | 0.02 |
| F40 | 1.57 | 0.11 | 0.41 | 0.04 | 0.24 | 0.05 | 0.17 | 0.05 |
| F200 | 1.40 | 0.08 | 0.47 | 0.03 | 0.22 | 0.03 | 0.25 | 0.04 |
| C1 | * | * | * | * | ||||
| C2 | ns | ns | ns | ns | ||||
| C3 | ns | ns | ns | ns | ||||
| C4 | ns | ns | ns | ns | ||||
| Land Use | Aggregate Stability (AS) | |||
|---|---|---|---|---|
| Period 1 (Spring 2014) | Period 3 (Winter/Spring 2015) | |||
| % | % | |||
| σ | Σ | |||
| Layer 0–0.05 m | ||||
| Cc | 97.3 | 4.4 | 97.3 | 4.3 |
| Co | 98.0 | 2.8 | 99.8 | 0.7 |
| Cs | 99.4 | 0.9 | 98.4 | 2.6 |
| F40 | 84.0 | 22.3 | 45.0 | 4.2 |
| F200 | 97.3 | 4.8 | 99.4 | 0.9 |
| C1 | ns | * | ||
| C2 | ns | ns | ||
| C3 | ns | ns | ||
| C4 | ns | * | ||
| Layer 0.05–0.20 | ||||
| Cc | 31.1 | 28.8 | 34.0 | 22.9 |
| Co | 45.1 | 29.1 | 33.4 | 15.6 |
| Cs | 49.6 | 26.3 | 44.9 | 23.3 |
| F40 | 39.2 | 27.7 | 28.5 | 6.6 |
| F200 | 78.2 | 23.9 | 57.2 | 18.1 |
| C1 | ns | ns | ||
| C2 | ns | ns | ||
| C3 | ns | ns | ||
| C4 | * | * | ||
| Layer 0.20–0.40 | ||||
| Cc | 7.4 | 7.8 | 8.7 | 10.5 |
| Co | 19.0 | 7.5 | 17.5 | 8.5 |
| Cs | 11.6 | 7.1 | 8.9 | 6.9 |
| F40 | 8.0 | 5.9 | 13.0 | 6.3 |
| F200 | 26.3 | 10.1 | 30.0 | 8.0 |
| C1 | ns | * | ||
| C2 | ns | ns | ||
| C3 | ns | ns | ||
| C4 | * | * | ||
| Land Use | Fluorescein (µg Fluorescein g−1 Dried Soil h−1) | |||||||
|---|---|---|---|---|---|---|---|---|
| Period 1 (Spring 2014) | Period 2 (Summer 2015) | Period 3 (Winter/Spring 2015) | Period 4 (Spring/Summer 2015) | |||||
| Sx | Sx | Sx | Sx | |||||
| Layer 0–0.05 | ||||||||
| Cc | 75.8 | 6.9 | 88.2 | 5.5 | 96.3 | 4.6 | 109.5 | 3.5 |
| Co | 93.8 | 5.6 | 111.7 | 3.4 | 126.6 | 5.2 | 110.2 | 2.8 |
| Cs | 97.8 | 2.3 | 100.9 | 1.7 | 130.7 | 2.6 | 110.2 | 5.7 |
| F40 | 103.2 | 6.7 | 109.3 | 3.3 | 117.1 | 3.8 | 126.9 | 2.8 |
| F200 | 97.9 | 2.4 | 109.8 | 6.5 | 139.6 | 1.8 | 131.6 | 0.9 |
| C1 | ns | ns | ns | * | ||||
| C2 | * | * | * | ns | ||||
| C3 | ns | ns | ns | ns | ||||
| C4 | ns | ns | ns | ns | ||||
| Layer 0.05–0.20 | ||||||||
| Cc | 49.1 | 6.1 | 20.1 | 2.1 | 27.2 | 2.3 | 34.3 | 3.9 |
| Co | 23.0 | 2.7 | 23.4 | 4.2 | 22.6 | 6.8 | 13.7 | 3.3 |
| Cs | 30.6 | 5.4 | 12.7 | 2.0 | 20.2 | 3.5 | 15.2 | 1.4 |
| F40 | 76.5 | 7.9 | 28.7 | 1.4 | 39.1 | 6.5 | 40.2 | 8.8 |
| F200 | 57.3 | 3.7 | 49.1 | 9.9 | 106.2 | 10.7 | 114.7 | 4.3 |
| C1 | ns | ns | ns | ns | ||||
| C2 | ns | ns | ns | ns | ||||
| C3 | ns | ns | ns | ns | ||||
| C4 | ns | ns | ns | ns | ||||
| Layer 0.2 to 0.40 | ||||||||
| Cc | 19.1 | 1.5 | 21.0 | 2.3 | 23.8 | 8.4 | 40.0 | 6.9 |
| Co | 10.1 | 1.6 | 5.0 | 1.0 | 6.2 | 1.7 | 12.0 | 2.9 |
| Cs | 3.2 | 1.0 | 1.3 | 0.6 | 5.3 | 0.8 | 4.4 | 5.7 |
| F40 | 45.9 | 12.9 | 23.0 | 1.9 | 25.0 | 5.4 | 21.8 | 6.1 |
| F200 | 34.2 | 4.3 | 46.8 | 12.2 | 67.2 | 13.6 | 86.0 | 9.3 |
| C1 | ns | ns | ns | ns | ||||
| C2 | ns | ns | ns | ns | ||||
| C3 | ns | ns | ns | ns | ||||
| C4 | ns | ns | ns | ns | ||||
Disclaimer/Publisher’s Note: The statements, opinions and data contained in all publications are solely those of the individual author(s) and contributor(s) and not of MDPI and/or the editor(s). MDPI and/or the editor(s) disclaim responsibility for any injury to people or property resulting from any ideas, methods, instructions or products referred to in the content. |
© 2023 by the authors. Licensee MDPI, Basel, Switzerland. This article is an open access article distributed under the terms and conditions of the Creative Commons Attribution (CC BY) license (https://creativecommons.org/licenses/by/4.0/).
Share and Cite
Pilon, L.C.; Ambus, J.V.; Blume, E.; Jacques, R.J.S.; Reichert, J.M. Citrus Orchards in Agroforestry, Organic, and Conventional Systems: Soil Quality and Functioning. Sustainability 2023, 15, 13060. https://doi.org/10.3390/su151713060
Pilon LC, Ambus JV, Blume E, Jacques RJS, Reichert JM. Citrus Orchards in Agroforestry, Organic, and Conventional Systems: Soil Quality and Functioning. Sustainability. 2023; 15(17):13060. https://doi.org/10.3390/su151713060
Chicago/Turabian StylePilon, Lucas Contarato, Jordano Vaz Ambus, Elena Blume, Rodrigo Josemar Seminoti Jacques, and José Miguel Reichert. 2023. "Citrus Orchards in Agroforestry, Organic, and Conventional Systems: Soil Quality and Functioning" Sustainability 15, no. 17: 13060. https://doi.org/10.3390/su151713060
APA StylePilon, L. C., Ambus, J. V., Blume, E., Jacques, R. J. S., & Reichert, J. M. (2023). Citrus Orchards in Agroforestry, Organic, and Conventional Systems: Soil Quality and Functioning. Sustainability, 15(17), 13060. https://doi.org/10.3390/su151713060

